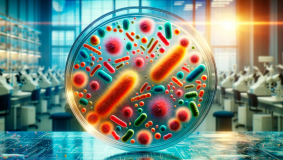
AP26193911 &ndash; Өсімдіктердегі этилендік стресті төмендету үшін АЦК деаминаза өндіретін бактериялардан синтетикалық микробиомаларды ғылыми негіздеу, әзірлеу және сынау

Университеттің ғылыми жобалары
Қ.И. Сәтбаев атындағы Қазақ ұлттық техникалық зерттеу университетінің ең маңызды жетістіктерінің бірі – өндіріске ұсынылған және енгізілген ғылыми технологиялар болып табылады.
Зерттеулердің негізгі басым бағыттары:
- Экология, қоршаған орта және табиғатты ұтымды пайдалану
- Энергетика, озық материалдар және транспорт
- Озық өндіріс, цифрлық және ғарыштық технологиялар
- Өмір және денсаулық туралы ғылым
- Агроөнеркәсіптік кешеннің тұрақты дамыту
- Елдің зияткерлік әлеуеті
- Ұлттық қауіпсіздік және қорғаныс, биологиялық қауіпсіздік
Жұмыстың басым міндеттері - жаңа білім алу; отандық технологияларды жасау және коммерцияландыру үшін қажетті серіктестік тетіктерін қалыптастыру; инновациялық қызметті қаржылық қолдау жүйесін жетілдіру; ғылыми-техникалық және зияткерлік әлеуетті дамыту және инновациялық экономика саласын дамытудың өзге де маңызды мәселелерін шешу болып табылады.
Қ.И. Сәтбаев атындағы Қазақ ұлттық техникалық зерттеу университеті - елдегі инновациялық ғылыми зерттеулердің көшбасшысы. Университеттің ғалымдары мен оқытушылары әлемдік жетекші журналдарда мақалалар жариялайды, өнертабыстар, патенттер және авторлық куәліктер саны артып келеді. Университет өндіріс орындарымен тығыз байланыста жұмыс істей отырып, шаруашылық субъектілерінің өзекті мәселелерін шешуге бағытталған іргелі және қолданбалы идеяларды қалыптастырады.
Университет зерттеушілері еліміздің еңбек нарығында жоғары бағаланады және шетелдегі беделді симпозиумдар мен конференцияларда мойындалып келеді. Олар білім мен технологиялардың жаңа салаларын белсенді игеріп, ғылыми-техникалық зерттеулердің нәтижелерін идеядан бастап өндіріске енгізуге дейінгі инновациялық тізбек бойынша жүзеге асырады.
Университет өзінің болашағын алдағы төртінші индустриялық революциямен байланыстыра отырып, ғылыми жұмысты алдағы жылдарға жоспарлайды.